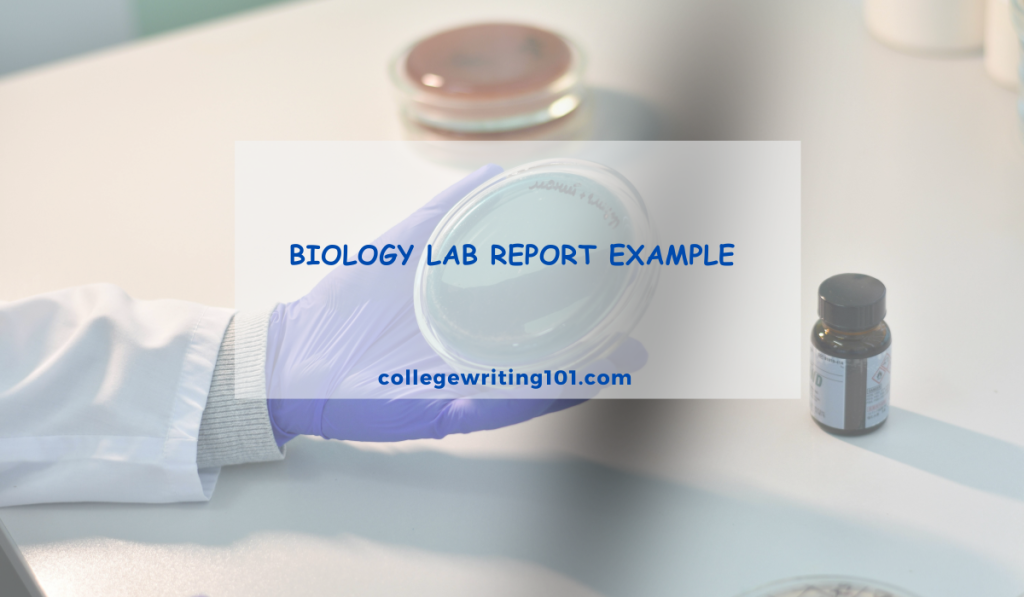
Biology Lab Report Example

Writing a biology lab report can feel confusing, especially if you are not sure what instructors expect. Lab reports are not just summaries of experiments; they explain why the experiment was done, how it was conducted, what results were found, and what those results mean. By looking at a clear example, students can learn how to organize sections such as the introduction, methods, results, and discussion. A good example also shows how to present data, write observations clearly, and use scientific language correctly.
What Is a Biology Lab Report?
A biology lab report is a formal scientific document that records the details and outcomes of a laboratory experiment or research study. It serves as both a record of your work and a communication tool that allows others to understand, evaluate, and potentially replicate your findings.
Think of it as telling the story of your experiment in a standardized format that scientists worldwide recognize. The report typically includes several key components: an abstract summarizing the entire study, an introduction explaining the scientific context and hypothesis, a materials and methods section detailing your experimental procedures, a results section presenting your data, and a discussion analyzing what your findings mean.
Unlike casual observation notes, lab reports follow strict conventions. They’re written in past tense, use third person perspective, and maintain an objective, professional tone throughout. The goal isn’t to prove you were right, but to honestly document what happened during your experiment—whether results supported your hypothesis or not.

Standard Biology Lab Report Format
1. Title Page
- Title: Clear, concise, and descriptive (e.g., “The Effect of pH on Catalase Enzyme Activity in Liver Tissue”).
- Your Name & Lab Partners’ Names
- Course Name & Code (e.g., Biology 101)
- Instructor’s Name
- Date (Date of experiment or submission)
- Lab Section/Group Number (if applicable)
2. Introduction
- Purpose: Provides background, context, and the report’s objective.
- Structure:
- Background: Introduce the broader biological concept. Cite relevant theories and previous knowledge.
- Specific Focus: Narrow down to the experiment’s specific topic. Define key terms.
- Statement of Purpose: Clearly state what you intended to investigate (e.g., “The purpose of this experiment was to…”).
- Hypothesis: A testable, measurable prediction written as an “If…then…” statement (e.g., “If the pH increases from neutral to basic, then the rate of catalase activity will decrease.”). Include a rationale explaining the scientific reasoning behind your prediction.
3. Materials and Methods (Procedure)
- Purpose: Allows others to replicate your experiment.
- Materials: A bulleted or numbered list of all equipment, specimens, and chemicals used (include concentrations and quantities).
- Methods:
- Describe the experimental procedure in chronological order.
- Use past tense and passive voice (e.g., “Five mL of substrate was added…”).
- Be detailed but concise. Do not copy the lab manual verbatim.
- Include descriptions of:
- Experimental Setup & Groups (Control, Experimental, number of trials).
- Variables: Identify the Independent Variable (IV), Dependent Variable (DV), and controlled variables.
- Data Collection: How and when measurements were taken.
- Statistical Tests (if any) used for analysis.
4. Results
- Purpose: Objectively present the collected data.
- Key Rules:
- No interpretation or explanation here—just facts.
- Use text, tables, and figures (graphs, charts, drawings).
- Structure:
- Textual Summary: Begin with a paragraph pointing out the most important trends. Reference all tables and figures (e.g., “As shown in Figure 1, enzyme activity peaked at pH 7.”).
- Tables: Numbered (Table 1, Table 2) with descriptive titles. Clearly label rows/columns with units.
- Figures: Numbered (Figure 1, Figure 2). Graphs must include:
- A descriptive title (often placed below the graph).
- Labeled axes with units.
- A clear legend if multiple data sets are shown.
- Error bars (standard deviation/error) for quantitative studies.
- Include sample calculations if applicable (often in an appendix).
5. Discussion
- Purpose: Interpret your results, explain their significance, and address the hypothesis.
- Structure:
- Restate the Hypothesis & Key Findings: Briefly reiterate the purpose and main results.
- Interpretation: Explain what the results mean. Compare expected vs. actual outcomes.
- Support/Reject Hypothesis: Explicitly state whether the data supports or rejects your initial hypothesis.
- Explain the Science: Use biological principles to explain why you got these results. Link back to background from the Introduction.
- Error Analysis: Discuss sources of error (human, instrumental, methodological). Be specific—avoid “human error.” Explain how they might have affected the results and suggest concrete improvements for future experiments.
- Broader Implications & Future Questions: Relate findings to the real world or broader theory. Pose new questions that arise from your experiment.
6. Conclusion
- A short, separate section (or final paragraph of the Discussion in some formats).
- Succinctly summarize the experiment’s overall outcome and its importance.
- Answer the question: “What is the single most important thing you learned?”
7. References (Literature Cited)
- List all external sources (textbooks, journal articles, lab manual, reputable websites) cited in your report.
- Use a consistent citation style (e.g., APA, MLA, CSE).
8. Appendices (if necessary)
- Include raw data sheets, extensive calculations, or supplemental materials not essential to the main flow of the report.
General Formatting Tips:
- Font: 12-point, legible (Times New Roman, Arial).
- Spacing: Often double-spaced.
- Margins: 1-inch on all sides.
- Page Numbers.
- Third-Person, Past Tense: Write objectively (avoid “I,” “we,” “my”).
- Passive Voice is Common: “The solution was heated” vs. “I heated the solution.”
- Units: Always use metric units (mL, cm, °C, g).
- Scientific Names: Italicized, genus capitalized (e.g., Drosophila melanogaster).
Biology Lab Report Example (Sample)
The Effect of Temperature on Catalase Enzyme Activity in Hydrogen Peroxide Decomposition
Introduction
Enzymes are biological catalysts that accelerate chemical reactions in living organisms by lowering activation energy requirements. Catalase, found in nearly all living organisms exposed to oxygen, catalyzes the decomposition of hydrogen peroxide (H₂O₂) into water and oxygen gas according to the equation: 2H₂O₂ → 2H₂O + O₂. This reaction is vital for cellular health because hydrogen peroxide is a toxic byproduct of normal metabolism that can damage cellular components if allowed to accumulate.
Like all proteins, enzymes possess a specific three-dimensional structure essential for their function. The active site, where substrate molecules bind, depends on precise amino acid arrangement maintained by hydrogen bonds and other molecular interactions. Temperature affects these bonds and therefore influences enzyme activity. At low temperatures, molecular motion decreases, reducing the frequency of enzyme-substrate collisions. As temperature increases, molecular kinetic energy rises, increasing collision frequency and reaction rate. However, excessive heat disrupts the bonds maintaining protein structure, causing denaturation and loss of catalytic function.
Previous research has established that most human enzymes function optimally near body temperature (37°C), while enzymes from thermophilic bacteria can withstand much higher temperatures. Understanding temperature effects on enzyme activity has practical applications in food preservation, industrial processes, and medicine.
Research Question: How does temperature affect the catalytic activity of catalase enzyme?
Hypothesis: Catalase activity will increase with rising temperature until reaching an optimal temperature around 40°C, after which activity will decrease significantly as the enzyme denatures at higher temperatures.
Materials and Methods
Materials
- Fresh potato (source of catalase)
- 3% hydrogen peroxide solution
- Distilled water
- Blender
- Cheesecloth
- 5 test tubes (25 mL capacity)
- 5 beakers (250 mL capacity)
- Graduated cylinders (10 mL and 100 mL)
- Rubber stoppers with gas collection tubes
- 5 inverted graduated cylinders for gas collection (50 mL capacity)
- Water bath apparatus
- Thermometers
- Ice bath
- Hot plate
- Stopwatch
- pH meter
Procedure
Enzyme Extract Preparation: A 50 g sample of fresh potato was peeled, cut into small cubes, and homogenized with 100 mL of distilled water in a blender for 2 minutes. The homogenate was filtered through four layers of cheesecloth into a beaker, yielding approximately 80 mL of crude catalase extract. The extract was kept on ice until use.
Temperature Setup: Five water baths were prepared and maintained at the following temperatures: 0°C (ice bath), 20°C (room temperature), 40°C, 60°C, and 80°C. Temperature was monitored continuously and maintained within ±2°C of the target.
Experimental Procedure: For each temperature condition, 5 mL of enzyme extract was placed in a test tube and equilibrated in the appropriate water bath for 5 minutes. A graduated cylinder was filled with water, inverted in a water-filled beaker, and positioned to collect gas. The gas collection tube was inserted through the rubber stopper.
After equilibration, 5 mL of 3% hydrogen peroxide (also pre-equilibrated to the test temperature) was quickly added to the enzyme extract, and the test tube was immediately sealed with the stopper. Oxygen production was measured by recording the volume of gas collected in the inverted graduated cylinder at 30-second intervals for 3 minutes. Three trials were conducted for each temperature, and the test tubes were swirled gently every 30 seconds to ensure mixing.
Data Collection: The volume of oxygen gas collected was recorded at each time point. Reaction rate was calculated by dividing the total oxygen volume collected by the time elapsed. The pH of each enzyme-substrate mixture was measured after the reaction and remained between 6.8-7.2 for all trials.
Results
Temperature had a significant effect on catalase enzyme activity, as measured by oxygen gas production during hydrogen peroxide decomposition. Table 1 presents the mean oxygen volumes collected at each temperature after 3 minutes of reaction time.
Table 1: Oxygen Production at Different Temperatures
| Temperature (°C) | Trial 1 (mL) | Trial 2 (mL) | Trial 3 (mL) | Mean (mL) | Standard Deviation | Reaction Rate (mL O₂/min) |
|---|---|---|---|---|---|---|
| 0 | 33 | 38 | 36 | 35.7 | 2.5 | 11.9 |
| 20 | 98 | 102 | 95 | 98.3 | 3.5 | 32.8 |
| 40 | 132 | 138 | 135 | 135.0 | 3.0 | 45.0 |
| 60 | 67 | 71 | 69 | 69.0 | 2.0 | 23.0 |
| 80 | 22 | 26 | 24 | 24.0 | 2.0 | 8.0 |
At 0°C, enzyme activity was substantially reduced, with an average of 35.7 mL of oxygen produced and a reaction rate of 11.9 mL O₂/min. Activity increased markedly at room temperature (20°C), reaching 98.3 mL total oxygen production and a rate of 32.8 mL O₂/min. Optimal enzyme activity occurred at 40°C, where 135.0 mL of oxygen was collected with a reaction rate of 45.0 mL O₂/min—nearly four times greater than activity at 0°C.
Beyond the optimal temperature, enzyme activity declined sharply. At 60°C, oxygen production decreased to 69.0 mL (23.0 mL O₂/min), and at 80°C, activity was severely inhibited with only 24.0 mL of oxygen collected (8.0 mL O₂/min)—even lower than activity observed at 0°C.
Figure 1 illustrates the relationship between temperature and reaction rate, showing a clear peak at 40°C with declining activity at both lower and higher temperatures. The graph demonstrates a typical enzyme-temperature response curve with an ascending phase from 0°C to 40°C and a descending phase from 40°C to 80°C.
Standard deviations remained relatively small across all trials (2.0-3.5 mL), indicating consistent and reliable measurements.
Discussion
The experimental results supported our hypothesis that catalase enzyme activity would increase with temperature up to an optimal point and then decrease at higher temperatures. The data clearly demonstrated that temperature is a critical factor influencing enzyme function.
Interpretation of Results: The low activity observed at 0°C can be attributed to decreased molecular kinetic energy, which reduces the frequency and effectiveness of enzyme-substrate collisions. As temperature increased to 20°C and 40°C, molecular motion accelerated, increasing collision rates and allowing more substrate molecules to bind to the enzyme’s active site. The optimal activity at 40°C aligns with expected values for plant-derived enzymes and is consistent with temperatures that maintain protein structure while maximizing reaction kinetics.
The sharp decline in activity at 60°C and 80°C indicates thermal denaturation of the catalase enzyme. At these elevated temperatures, the thermal energy disrupts hydrogen bonds and other weak interactions that maintain the enzyme’s three-dimensional structure. Once denatured, the active site loses its precise configuration, preventing effective substrate binding and catalysis. The fact that activity at 80°C was lower than at 0°C suggests that denaturation represents irreversible structural damage, whereas cold temperatures merely slow molecular motion without permanently altering protein structure.
Comparison to Existing Research: These findings are consistent with established literature on enzyme kinetics. Most plant and animal enzymes exhibit optimal activity between 35-45°C, with significant loss of function above 50-60°C. The bell-shaped temperature-activity curve observed in this experiment is characteristic of enzyme behavior and has been documented extensively in studies of various enzymes across different organisms.
Experimental Limitations: Several limitations should be acknowledged. First, the crude potato extract likely contained multiple enzymes and proteins, not just purified catalase, which could have influenced results. Second, we did not measure the exact enzyme concentration, making it difficult to calculate specific activity values. Third, temperature control, while generally maintained within ±2°C, may have fluctuated during substrate addition. Finally, we did not account for potential pH changes that might have occurred during the reaction, although post-reaction measurements suggested pH remained relatively stable.
Sources of Error: Measurement error in gas collection could have occurred due to gas solubility in water or small leaks in the collection apparatus. The brief exposure to room temperature during hydrogen peroxide addition may have affected initial reaction conditions, particularly for the extreme temperature trials. Additionally, the 5-minute equilibration time may not have been sufficient for complete temperature equilibration of the enzyme solution.
Future Directions: Future experiments could investigate a narrower temperature range around the optimal point (35-45°C in 1°C increments) to more precisely determine the temperature optimum. Using purified catalase enzyme would eliminate confounding variables from crude extracts. Examining the effect of pre-incubation time at high temperatures could clarify the kinetics of thermal denaturation. Additionally, testing catalase from different organisms (bacteria, fungi, animals) would reveal whether optimal temperatures correlate with organisms’ native environments.
Broader Implications: Understanding temperature effects on enzyme activity has practical significance. In food preservation, refrigeration and freezing slow enzymatic reactions that cause spoilage. In industrial biotechnology, maintaining optimal temperatures maximizes enzyme efficiency in processes like brewing, cheese production, and biofuel generation. Medically, fever represents the body’s attempt to inhibit pathogen enzyme function while maintaining human enzyme activity. These results reinforce the importance of homeostasis in maintaining optimal conditions for life’s biochemical processes.
Conclusion
This experiment successfully demonstrated that temperature significantly affects catalase enzyme activity during hydrogen peroxide decomposition. The optimal temperature of 40°C produced the highest reaction rate (45.0 mL O₂/min), while both lower temperatures (reduced molecular motion) and higher temperatures (protein denaturation) resulted in decreased enzyme activity. The bell-shaped temperature-activity curve confirmed established principles of enzyme kinetics and highlighted the narrow temperature range in which enzymes function most effectively. These findings emphasize the critical importance of temperature regulation in biological systems and have applications in fields ranging from medicine to industrial biotechnology.
References
Campbell, N. A., & Reece, J. B. (2022). Biology (12th ed.). Pearson Education.
Cooper, G. M., & Hausman, R. E. (2021). The Cell: A Molecular Approach (8th ed.). Sinauer Associates.
Nelson, D. L., & Cox, M. M. (2021). Lehninger Principles of Biochemistry (8th ed.). W. H. Freeman.
Nicholls, P. (1964). The formation and properties of sulphmyoglobin and sulphcatalase. Biochemical Journal, 81(2), 374-383.
Sumner, J. B., & Dounce, A. L. (1937). Crystalline catalase. Journal of Biological Chemistry, 121(2), 417-424.
Appendix
Appendix A: Raw Data Tables
Trial 1 – Oxygen Production Over Time (mL)
| Time (sec) | 0°C | 20°C | 40°C | 60°C | 80°C |
|---|---|---|---|---|---|
| 30 | 8 | 25 | 35 | 18 | 6 |
| 60 | 14 | 42 | 61 | 30 | 10 |
| 90 | 20 | 62 | 86 | 42 | 14 |
| 120 | 25 | 78 | 107 | 52 | 18 |
| 150 | 29 | 89 | 122 | 60 | 20 |
| 180 | 33 | 98 | 132 | 67 | 22 |
Appendix B: Sample Calculations
Reaction Rate Calculation for 40°C:
- Total oxygen produced = 135.0 mL (mean of three trials)
- Total time = 3 minutes
- Reaction rate = 135.0 mL ÷ 3 min = 45.0 mL O₂/min
Standard Deviation Calculation for 40°C:
- Values: 132, 138, 135 mL
- Mean = 135.0 mL
- Variance = [(132-135)² + (138-135)² + (135-135)²] ÷ 3 = 18 ÷ 3 = 6
- Standard deviation = √6 = 2.45 ≈ 3.0 mL
FAQs
Can ChatGPT write a lab report?
Yes, it can generate a structured draft, but it cannot conduct the experiment, produce original data, or provide authentic analysis. Its output is a template based on patterns and requires heavy editing, fact-checking, and insertion of your actual results. Using it without substantial contribution is considered academic dishonesty.
How to write a brief lab report?
Condense the standard format into four key sections:
Objective & Hypothesis (What you tested and predicted).
Methods & Materials (A very concise procedure).
Results (Key data/trends with one clear graph or table).
Discussion & Conclusion (Briefly interpret results, state if hypothesis was supported, and note major sources of error).
What are the 9 components of a lab report?
Title Page
Abstract
Introduction
Materials & Methods
Results
Discussion
Conclusion
References
Appendices (if needed)